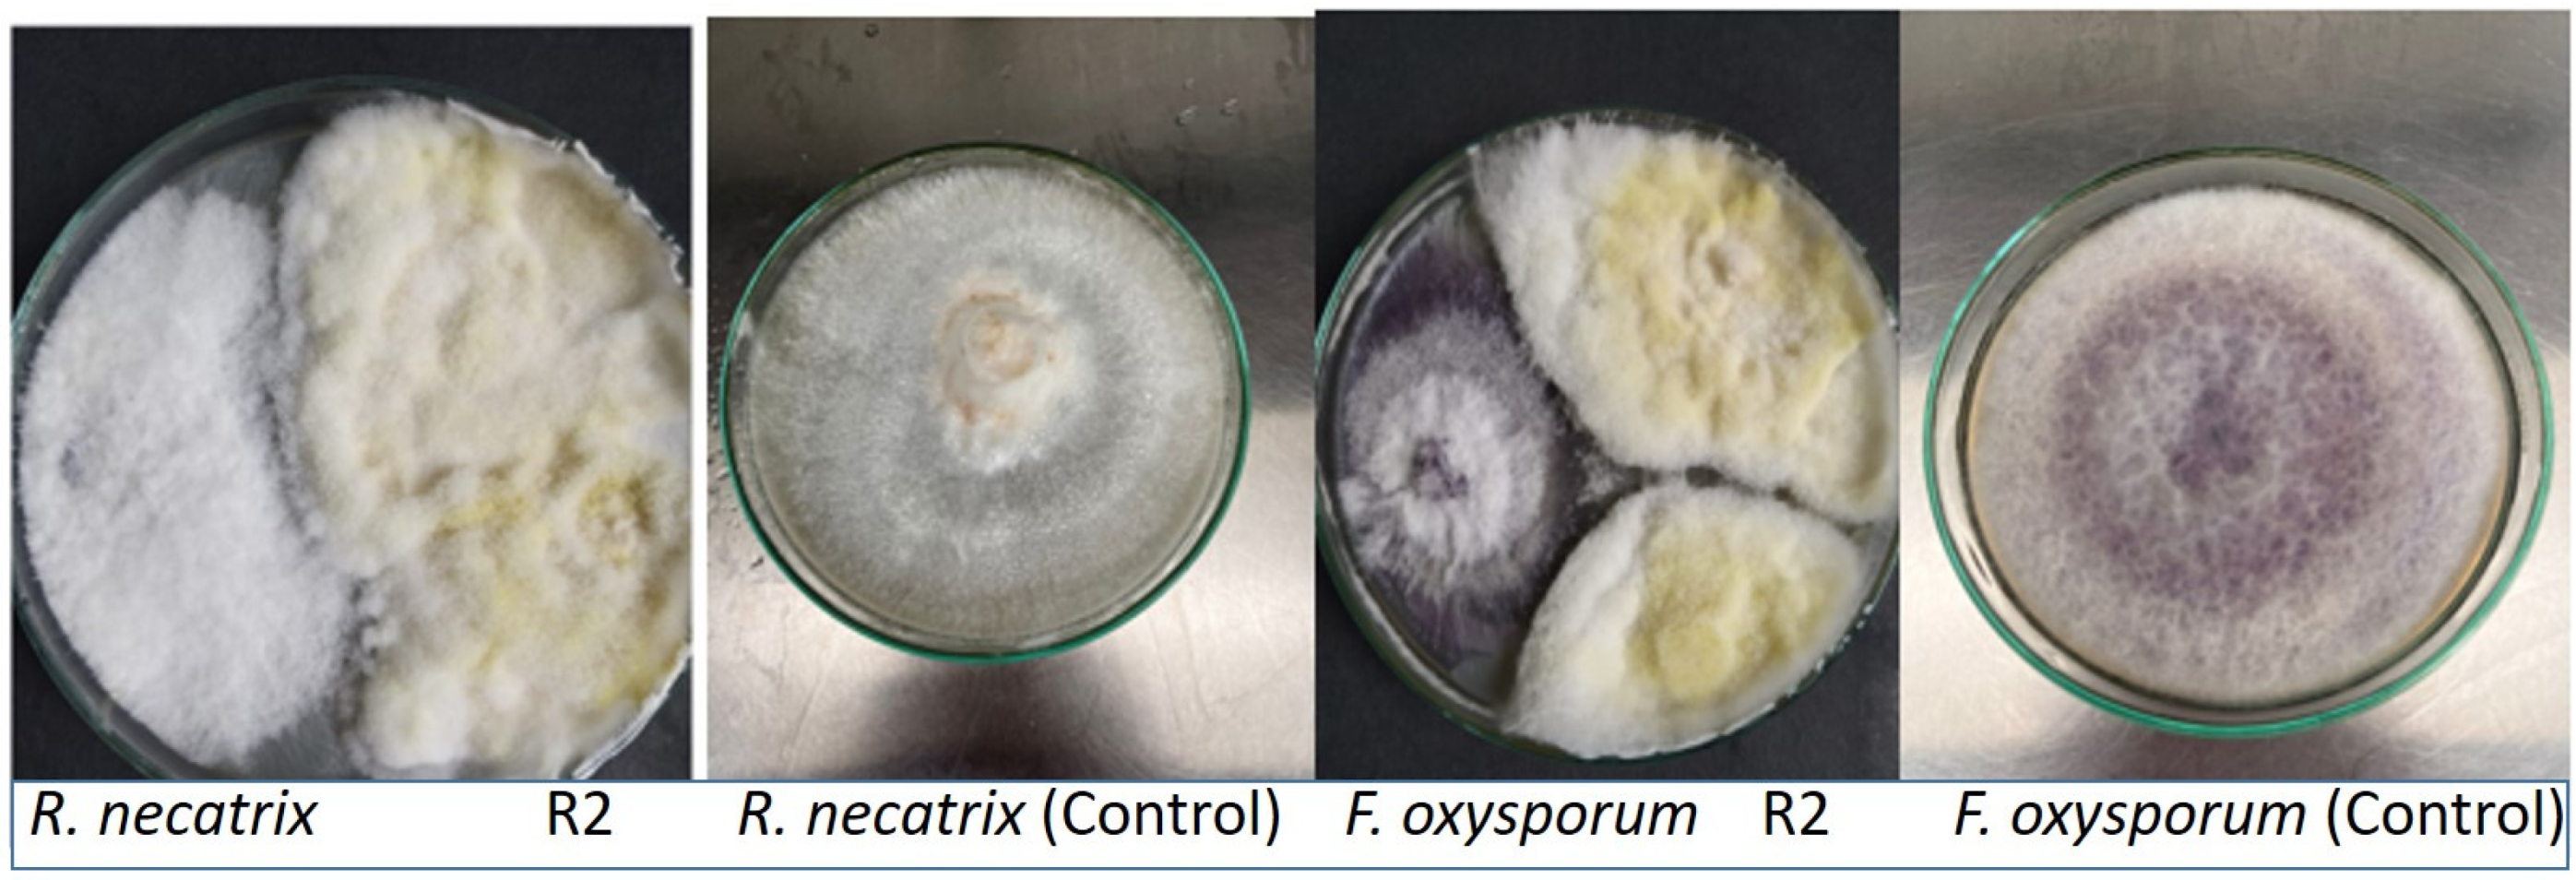
Plants 12 01151 g001 Plants 12 01151 g001

Improvement in the Phytochemical Content and Biological Properties of Stevia rebaudiana (Bertoni) Bertoni Plant Using Endophytic Fungi Fusarium fujikuroi
Abstract
1. Introduction
2. Results
2.1. Isolation and Morphological Characteristics of Endophytic Fungi
2.2. Antagonistic Impact of Endophytic Fungi against Plant Pathogenic Fungi
2.3. Aligned Sequence Data of Sample—Fusarium Fujikuroi (551 bp)
ITS1-5.8S rRNA-ITS2 Region Sequences Analyzed Phylogenetically
2.4. Antioxidant Assay
2.4.1. DPPH Assay
2.4.2. FRAP Assay
2.5. UHPLC (Ultra-High-Performance Liquid Chromatography)
3. Materials and Methodology
3.1. Sample Collection
3.2. Endophytic Fungi Isolation and Cultivation
3.3. Fungal Isolates for Antagonistic Activity
3.4. DNA Extraction and PCR Amplification
3.4.1. DNA Extractions
3.4.2. Quantity and Quality Determination
3.4.3. Sequence Alignment and Phylogenetic Analysis
3.5. Preparation of Fungal Inoculum
3.5.1. Inoculation Method
3.5.2. Plant Extracts Preparation
3.6. Antioxidant Activity
3.6.1. 2,2-Diphenyl-1-Picrylhydrazyl (DPPH) Radical Scavenging Activity
3.6.2. FRAP Assay
3.7. UHPLC
3.8. Statistical Analysis
4. Discussion
5. Conclusions and Recommendations
Author Contributions
Funding
Data Availability Statement
Acknowledgments
Conflicts of Interest
References
- Dutta, D.; Puzari, K.C.; Gogoi, R.; Dutta, P. Endophytes: Exploitation as a tool in plant protection. Braz. Arch. Biol. Technol. 2014, 57, 621–629. [Google Scholar] [CrossRef]
- Tyagi, J.; Chaudhary, P.; Mishra, A.; Khatwani, M.; Dey, S.; Varma, A. Role of endophytes in abiotic stress tolerance: With special emphasis on Serendipita indica. Int. J. Environ. Rese. 2022, 16, 62. [Google Scholar] [CrossRef]
- Garyali, S.; Kumar, A.; Reddy, M.S. Taxol production by an endophytic fungus, Fusarium redolens, isolated from Himalayan yew. J. Microbiol. Biotechnol. 2013, 23, 1372–1380. [Google Scholar] [CrossRef]
- Ye, H.T.; Luo, S.Q.; Yang, Z.N.; Wang, Y.S.; Ding, Q.; Wang, K.F.; Yang, S.X.; Wang, Y. Endophytic fungi stimulate the concentration of medicinal secondary metabolites in Houttuynia cordata thunb. Plant Signal. Behavi. 2021, 16, 1929731. [Google Scholar] [CrossRef] [PubMed]
- Jia, M.; Chen, L.; Xin, H.L.; Zheng, C.J.; Rahman, K.; Han, T.; Qin, L.P. A friendly relationship between endophytic fungi and medicinal plants: A systematic review. Front Microbiol. 2016, 9, 906. [Google Scholar] [CrossRef]
- Lai, D.; Mao, Z.; Zhou, Z.; Zhao, S.; Xue, M.; Dai, J.; Zhou, L.; Li, D. New chlamydosporol derivatives from the endophytic fungus Pleosporales sp. Sigrf05 and their cytotoxic and antimicrobial activities. Sci. Rep. 2020, 10, 8193. [Google Scholar] [CrossRef]
- Mao, Z.; Xue, M.; Gu, G.; Wang, W.; Li, D.; Lai, D.; Zhou, L. Lophiostomin A–D: New 3, 4-dihydroisocoumarin derivatives from the endophytic fungus Lophiostoma sp. Sigrf10. RSC Adv. 2020, 10, 6985–6991. [Google Scholar] [CrossRef]
- Kumar, M.; Yadav, V.; Tuteja, N.; Johri, A.K. Antioxidant enzyme activities in maize plants colonized with Piriformospora indica. Microbiology 2009, 155, 780–790. [Google Scholar] [CrossRef]
- Janevska, S.; Tudzynski, B. Secondary metabolism in Fusarium fujikuroi: Strategies to unravel the function of biosynthetic pathways. Appl. Microbiol. Biotechnol. 2018, 102, 615–630. [Google Scholar] [CrossRef]
- Prakash, P.A.; Gupta, N. Therapeutic uses of Ocimum sanctum Linn (Tulsi) with a note on eugenol and its pharmacological actions: A short review. Indian J. Physiol. Pharmacol. 2005, 49, 125. [Google Scholar]
- Pattanayak, P.; Behera, P.; Das, D.; Panda, S.K. Ocimum sanctum Linn. A reservoir plant for therapeutic applications: An overview. Pharmacogn. Rev. 2010, 4, 95–105. [Google Scholar] [CrossRef] [PubMed]
- Bhattacharjya, D.; Adhikari, S.; Biswas, A.; Bhuimali, A.; Ghosh, P.; Saha, S. Ocimum phytochemicals and their potential impact on human health. Phytochemicals in Human Health. 2019, 23, 1–26. [Google Scholar]
- Satyendra, M. Phytochemical efficiency of Ocimum sanctum (Tulsi) in health enhancement and disease prevention: A review. IJARESM 2020, 9, 1346–1351. [Google Scholar]
- Benelli, G.; Pavela, R.; Drenaggi, E.; Desneux, N.; Maggi, F. Phytol, (E)-nerolidol and spathulenol from Stevia rebaudiana leaf essential oil as effective and eco-friendly botanical insecticides against Metopolophium dirhodum. Ind. Crop. Prod. 2020, 155, 112844. [Google Scholar] [CrossRef]
- Available online: http://eagri.tnau.ac.in/eagri50/HORT282/pdf/lec34.pdF (accessed on 10 April 2016).
- Crammer, B.; Ikan, R. Sweet glycosides from the Stevia plant. Chem. Ber. 1986, 22, 915–917. [Google Scholar]
- Huang, Y.; Zhao, J.; Zhou, L.; Wang, M.; Wang, J.; Li, X.; Chen, Q. Antimicrobial compounds from the endophytic fungus Fusarium sp. Ppf4 isolated from the medicinal plant Paris polyphylla var. yunnanensis. Nat. Prod. Commun. 2009, 4, 1455–1458. [Google Scholar] [CrossRef]
- Cui, W.G.; Zheng, H.L.; Zhang, F.B.; Swingle, B.; Zhu, H.T.; Gao, M. First report of Rhizopus oryzae causing potato soft rot in the hebei province of China. Plant Dis. 2019, 103, 773. [Google Scholar] [CrossRef]
- Vinayarani, G.; Prakash, H.S. Fungal endophytes of turmeric (Curcuma longa L.) and their biocontrol potential against pathogens Pythium aphanidermatum and Rhizoctonia solani. World J. Microbiol. Biotechnol. 2018, 34, 49. [Google Scholar] [CrossRef]
- Guo, L.D.; Hyde, K.D.; Liew, E.C. Identification of endophytic fungi from Livistona chinensis based on morphology and rDNA sequences. New Phytol. 2000, 147, 617–630. [Google Scholar] [CrossRef]
- Aamir, S.; Sutar, S.; Singh, S.K.; Baghela, A. A rapid and efficient method of fungal genomic DNA extraction, suitable for PCR based molecular methods. Plant Pathol. Quar. 2015, 5, 74–81. [Google Scholar] [CrossRef]
- Bhardwaj, A.; Sharma, D.; Jadon, N.; Agrawal, P.K. Antimicrobial and phytochemical screening of endophytic fungi isolated from spikes of Pinus roxburghii. Arch. Clin. Microbiol. 2015, 6, 1–9. [Google Scholar]
- Singh, S.P.; Gaur, R. Evaluation of antagonistic and plant growth promoting activities of chitinolytic endophytic actinomycetes associated with medicinal plants against Sclerotium rolfsii in chickpea. J. Appl. Microbiol. 2016, 121, 506–518. [Google Scholar] [CrossRef] [PubMed]
- Behera, B.; Sinha, P.; Gouda, S.; Rath, S.K.; Barik, D.P.; Jena, P.K.; Panda, P.C.; Naik, S.K. In Vitro propagation by axillary shoot proliferation, assessment of antioxidant activity, and genetic fidelity of micropropagated Paederia foetida L. J. Appl. Biol. Biotechnol. 2018, 6, 4–9. [Google Scholar]
- Katalinic, V.; Milos, M.; Kulisic, T.; Jukic, M. Screening of 70 medicinal plant extracts for antioxidant capacity and total phenols. Food Chem. 2006, 94, 550–557. [Google Scholar] [CrossRef]
- Benzie, I.F.; Strain, J.J. The ferric reducing ability of plasma (FRAP) as a measure of “antioxidant power”: The FRAP assay. Anal. Biochem. 1996, 239, 70–76. [Google Scholar] [CrossRef] [PubMed]
- Kaur, N.; Arora, D.S.; Kalia, N.; Kaur, M. Antibiofilm, antiproliferative, antioxidant and antimutagenic activities of an endophytic fungus Aspergillus fumigatus from Moringa oleifera. Mol. Biol. Rep. 2020, 47, 2901–2911. [Google Scholar] [CrossRef]
- Hussein, H.G.; E.l-Sayed, E.S.; Younis, N.A.; Hamdy, A.E.; Easa, S.M. Harnessing endophytic fungi for biosynthesis of selenium nanoparticles and exploring their bioactivities. AMB Express 2022, 12, 68. [Google Scholar] [CrossRef]
- El-Sayed, E.S.; Hazaa, M.A.; Shebl, M.M.; Amer, M.; Mahmoud, S.R.; Khattab, A.A. Bioprospecting endophytic fungi for bioactive metabolites and use of irradiation to improve their bioactivities. AMB Express 2022, 12, 46. [Google Scholar] [CrossRef]
- Hashem, A.H.; Shehabeldine, A.M.; Abdelaziz, A.M.; Amin, B.H.; Sharaf, M.H. Antifungal activity of endophytic Aspergillus terreus extract against some fungi causing mucormycosis: Ultrastructural study. Appl. Biochem. Biotechnol. 2022, 194, 3468–3482. [Google Scholar] [CrossRef]
- Caicedo, N.H.; Davalos, A.F.; Puente, P.A.; Rodríguez, A.Y.; Caicedo, P.A. Antioxidant activity of exo-metabolites produced by Fusarium oxysporum: An endophytic fungus isolated from leaves of Otobagracilipes. Microbiol. Open 2019, 8, 903–910. [Google Scholar] [CrossRef]
- Fadiji, A.E.; Babalola, O.O. Elucidating mechanisms of endophytes used in plant protection and other bioactivities with multifunctional prospects. Front. Bioeng. Biotechnol. 2020, 8, 467. [Google Scholar] [CrossRef] [PubMed]
- Eid, A.M.; Salim, S.S.; Hassan, S.E.; Ismail, M.A.; Fouda, A. Role of endophytes in plant health and abiotic stress management. In Microbiome in Plant Health and Disease; Springer: Singapore, 2019; pp. 119–144. [Google Scholar]
- Hoque, M.N.; Tahjib-Ul-Arif, M.; Hannan, A.; Sultana, N.; Akhter, S.; Hasanuzzaman, M.; Akter, F.; Hossain, M.S.; Sayed, M.A.; Hasan, M.T.; et al. Melatonin modulates plant tolerance to heavy metal stress: Morphological responses to molecular mechanisms. Int. J. Mol. Sci. 2021, 22, 11445. [Google Scholar] [CrossRef] [PubMed]
- Han, D.; Wang, K.; Long, F.; Zhang, W.; Yao, X.; Chen, S. Effects of endophytic fungi on the secondary metabolites of Hordeum bogdanii under alkaline stress. AMB Express 2022, 12, 73. [Google Scholar] [CrossRef] [PubMed]
- Hasanuzzaman, M.; Bhuyan, M.B.; Zulfiqar, F.; Raza, A.; Mohsin, S.M.; Mahmud, J.A.; Fujita, M.; Fotopoulos, V. Reactive oxygen species and antioxidant defense in plants under abiotic stress: Revisiting the crucial role of a universal defense regulator. Antioxidants 2020, 9, 681. [Google Scholar] [CrossRef]
- Camehl, I.; Sherameti, I.; Venus, Y.; Bethke, G.; Varma, A.; Lee, J. Ethylene signalling and ethylene-targeted transcription factors are required to balance beneficial and nonbeneficial traits in the symbiosis between the endophytic fungus Piriformospora indica and Arabidopsis thaliana. New Phytol. 2010, 185, 1062–1073. [Google Scholar] [CrossRef]
- Alam, B.; Li, J.; Ge, Q.; Khan, M.A.; Gōng, J.; Mehmood, S.; Yuan, Y.; Gong, W. Endophytic fungi: From symbiosis to secondary metabolite communications or vice versa? Front. Plant Sci. 2021, 12, 3060. [Google Scholar] [CrossRef]
- Bajaj, R.; Huang, Y.; Gebrechristos, S.; Mikolajczyk, B.; Brown, H.; Prasad, R.; Varma, A.; Bushley, K.E. Transcriptional responses of soybean roots to colonization with the root endophytic fungus Piriformospora indica reveals altered phenylpropanoid and secondary metabolism. Sci. Rep. 2018, 8, 10227. [Google Scholar] [CrossRef]
- Ludwig-Müller, J. Plants and endophytes: Equal partners in secondary metabolite production? Biotechnol. Lett. 2015, 37, 1325–1334. [Google Scholar] [CrossRef]
- Cui, J.L.; Wang, Y.N.; Jiao, J.; Gong, Y.; Wang, J.H.; Wang, M.L. Fungal endophyte-induced salidroside and tyrosol biosynthesis combined with signal cross-talk and the mechanism of enzyme gene expression in Rhodiola crenulata. Sci. Rep. 2017, 7, 12540. [Google Scholar] [CrossRef]
- Scott, B.; Green, K.; Berry, D. The fine balance between mutualism and antagonism in the Epichloë festucae-grass symbiotic interaction. Curr. Opin. Plant Biol. 2018, 44, 32–38. [Google Scholar] [CrossRef]
- Maggin, V.; De Leo, M.; Mengoni, A. Plant-endophytes interaction influences the secondary metabolism in Echinacea purpurea (L.) Moench: An in vitro model. Sci. Rep. 2017, 7, 16924. [Google Scholar] [CrossRef] [PubMed]
- Ismail, A.H.; Mehmood, A.S.; Qadir, M.U.; Husna, A.I.; Hamayun, M.U.; Khan, N.A. Thermal stress alleviating potential of endophytic fungus Rhizopus oryzae inoculated to sunflower (Helianthus annuus L.) and soybean (Glycine max L.). Pak. J. Bot. 2020, 52, 1857–1865. [Google Scholar] [CrossRef] [PubMed]
- Bagheri, A.A.; Saadatmand, S.; Niknam, V.; Nejadsatari, T.; Babaeizad, V. Effect of endophytic fungus, Piriformospora indica, on growth and activity of antioxidant enzymes of rice (Oryza sativa L.) under salinity stress. Int. J. Adv. Biol. Biomed. Res. 2013, 1, 1337–1350. [Google Scholar]
- Guler, N.S.; Pehlivan, N.; Karaoglu, S.A.; Guzel, S.; Bozdeveci, A. Trichoderma atroviride ID20G inoculation ameliorates drought stress-induced damages by improving antioxidant defence in maize seedlings. Acta. Physiologiae. Plantarum. 2016, 38, 132. [Google Scholar] [CrossRef]
- Hamayun, M.; Hussain, A.; Iqbal, A.; Khan, S.A.; Khan, M.A.; Lee, I.J. An endophytic fungus Gliocladium cibotii regulates metabolic and antioxidant system of Glycine max and Helianthus annuus under heat stress. Pol. J. Environ. Stud. 2021, 30, 1631–1640. [Google Scholar]
- Jamwal, M.; Puri, S.; Prakash, S.; Sharma, S.; Pundir, A.; Singh, D. Yearly variation in biochemical composition, morphological aspects, and antimicrobial activities of Justicia adhatoda L. growing wildly in Western Himalayas. J. Appl. Biol. Biotechnol. 2022, 11, 61–65. [Google Scholar] [CrossRef]
- Atanassova, M.; Bagdassarian, V. Rutin content in plant products. J. Chem. Technol. Metall. 2009, 44, 201–203. [Google Scholar]
- Peres, D.A.; De Oliveira, C.A.; Da Costa, M.S.; Tokunaga, V.K.; Mota, J.P.; Rosado, C.; Consiglieri, V.O.; Kaneko, T.M.; Velasco, M.V.; Baby, A.R. Rutin increases critical wavelength of systems containing a single UV filter and with good skin compatibility. Skin Res. Technol. 2016, 22, 325–333. [Google Scholar] [CrossRef]
- Cardona, M.I.; Toro, R.M.; Costa, G.M.; Ospina, L.F.; Castellanos, L.; Ramos, F.A.; Aragón, D.M. Influence of extraction process on antioxidant activity and rutin content in Physalis peruviana calyces extract. J. Appl. Pharm. Sci. 2017, 7, 164–168. [Google Scholar]
- Prasad, K. Potential impact of seed coating with beneficial microorganisms to meticulousness sustainable organic agriculture for quality nutritive food production for modern lifestyle, improve global soil and environmental health towards green technology. Aditum J. Clin. Biomed. Res. 2021, 2, 1–9. [Google Scholar]
- Chen, M.; Yang, L.; Li, Q.; Shen, Y.; Shao, A.; Lin, S.; Huang, L. Volatile metabolites analysis and molecular identification of endophytic fungi bn12 from Cinnamomum camphora chvar. borneol. China Chin. Med. J. 2011, 36, 3217–3221. [Google Scholar]
- Guo, S.; Mao, W.; Li, Y.; Gu, Q.; Chen, Y.; Zhao, C.; Li, N.; Wang, C.; Guo, T.; Liu, X. Preparation, structural characterization and antioxidant activity of an extracellular polysaccharide produced by the fungus Oidiodendron truncatum GW. Process Biochem. 2013, 48, 539–544. [Google Scholar] [CrossRef]
- Dong, N.Q.; Lin, H.X. Contribution of phenylpropanoid metabolism to plant development and plant–environment interactions. J. Int. Plant Biol. 2020, 63, 180–209. [Google Scholar] [CrossRef] [PubMed]
- Wang, L.; Wu, W. Angiotensin-converting enzyme inhibiting ability of ethanol extracts, steviol glycosides and protein hydrolysates from Stevia leaves. Food Fun 2019, 10, 7967–7972. [Google Scholar] [CrossRef] [PubMed]
- Chen, J.; Li, L.; Tian, P.; Xiang, W.; Lu, X.; Huang, R.; Li, L. Fungal endophytes from medicinal plant Bletilla striata (Thunb.) Reichb. F. promote the host plant growth and phenolic accumulation. South African J. Bot. 2021, 143, 25–32. [Google Scholar] [CrossRef]
- Cappellari, L.R.; Chiappero, J.; Santoro, M.V.; Giordano, W.; Banchio, E. Inducing phenolic production and volatile organic compounds emission by inoculating Mentha piperita with plant growth-promoting Rhizobacteria. Sci. Hortic. 2017, 220, 193–198. [Google Scholar] [CrossRef]
- Kołodziej, B.; Kowalski, R.; Kędzia, B. Antibacterial and antimutagenic activity of extracts aboveground parts of three Solidago species: Solidago Virgaurea L., Solidago Canadensis L. and Solidago Gigantea Ait. J. Med. Plants Res. 2011, 5, 6770–6779. [Google Scholar] [CrossRef]
- Oliveira, A.S.; Ribeiro-Santos, R.; Ramos, F.; Castilho, M.C.; Sanches-Silva, A. UHPLC-DAD multi-method for determination of phenolics in aromatic plants. Food Anal. 2018, 11, 440–450. [Google Scholar] [CrossRef]
- Pacifico, S.; Piccolella, S.; Nocera, P.; Tranquillo, E.; Dal Poggetto, F.; Catauro, M. New insights into phenol and polyphenol composition of Stevia rebaudiana leaves. J. Pharmed. Biomed. Anal. 2019, 163, 45–57. [Google Scholar] [CrossRef]

| Pathogenic Fungi | Isolated Endophytic Fungi | Percentage of Growth Inhibition |
|---|---|---|
| Fusarium oxysporum | R1 | 38.09 ± 2.72 |
| R2 | 45.28 ± 2.72 | |
| R15 | 32.13 ± 3.09 | |
| Rosellinia necatrix | R11 | 26.98 ± 2.75 |
| R2 | 42.85 ± 2.75 | |
| R12 | 28.57 ± 2.38 |
| Peak Name | Methanolic Extract of Inoculated Plant | Methanolic Plant Extract (Control) | Chloroform Extract of Inoculated Plant | Chloroform Plant Extract (Control) | ||||||||
|---|---|---|---|---|---|---|---|---|---|---|---|---|
| Retention time Min | Relative Area % | Amount (mg/L) | Retention Time Min | Relative Area % | Amount (mg/L) | Retention Time Min | Relative Area % | Amount (mg/L) | Retention Time Min | Relative Area % | Amount (mg/L) | |
| Gallic acid | 2.41 | 1.78 | 0.04 | 2.44 | 1.52 | 0.01 | 2.42 | 5.23 | 0.06 | 2.28 | 0.11 | 0.08 |
| Caffeic acid | 3.08 | 2.86 | 0.55 | 3.07 | 5.22 | 0.46 | 3.06 | 7.38 | 0.18 | 3.06 | 6.41 | 0.10 |
| Syringic acid | 3.27 | 44.01 | 5.44 | 3.25 | 54.22 | 3.06 | 3.33 | 2.24 | 1.59 | 3.31 | 0.48 | 0.34 |
| Rutin | 8.593 | 93.08 | 20.8793 | 8.567 | 100 | 3.2362 | 8.707 | 100.00 | 5.1032 | 8.713 | 100.00 | 0.0818 |
| Quercetin | 14.700 | 2.42 | N.D. | N.D. | N.D. | N.D. | N.D. | N.D. | N.D. | N.D. | N.D. | N.D. |
| p-Coumaric acid | N.D. | N.D. | N.D. | N.D. | N.D. | N.D. | N.D. | N.D. | N.D. | N.D. | N.D. | N.D. |
| Salicylic acid | N.D. | N.D. | N.D. | N.D. | N.D. | N.D. | N.D. | N.D. | N.D. | N.D. | N.D. | N.D. |
| Total | 100.00 | 100.00 | 1.855 | 100.00 | 100.00 | |||||||
| S. No. | Oligo Name | Sequence (5`à 3`) | Tm (°C) | GC Content |
|---|---|---|---|---|
| 1. | ITS Forward | TCCGTAGGTGAACCTGCGG | 57 | 63.15% |
| 2. | ITS Reverse | TCCTCCGCTTATTGATATGC | 53 | 45% |
Disclaimer/Publisher’s Note: The statements, opinions and data contained in all publications are solely those of the individual author(s) and contributor(s) and not of MDPI and/or the editor(s). MDPI and/or the editor(s) disclaim responsibility for any injury to people or property resulting from any ideas, methods, instructions or products referred to in the content. |
© 2023 by the authors. Licensee MDPI, Basel, Switzerland. This article is an open access article distributed under the terms and conditions of the Creative Commons Attribution (CC BY) license (https://creativecommons.org/licenses/by/4.0/).
Share and Cite
Devi, R.; Abdulhaq, A.; Verma, R.; Sharma, K.; Kumar, D.; Kumar, A.; Tapwal, A.; Yadav, R.; Mohan, S. Improvement in the Phytochemical Content and Biological Properties of Stevia rebaudiana (Bertoni) Bertoni Plant Using Endophytic Fungi Fusarium fujikuroi. Plants 2023, 12, 1151. https://doi.org/10.3390/plants12051151
Devi R, Abdulhaq A, Verma R, Sharma K, Kumar D, Kumar A, Tapwal A, Yadav R, Mohan S. Improvement in the Phytochemical Content and Biological Properties of Stevia rebaudiana (Bertoni) Bertoni Plant Using Endophytic Fungi Fusarium fujikuroi. Plants. 2023; 12(5):1151. https://doi.org/10.3390/plants12051151
Chicago/Turabian StyleDevi, Reema, Ahmed Abdulhaq, Rachna Verma, Kiran Sharma, Dinesh Kumar, Ajay Kumar, Ashwani Tapwal, Rahul Yadav, and Syam Mohan. 2023. "Improvement in the Phytochemical Content and Biological Properties of Stevia rebaudiana (Bertoni) Bertoni Plant Using Endophytic Fungi Fusarium fujikuroi" Plants 12, no. 5: 1151. https://doi.org/10.3390/plants12051151
APA StyleDevi, R., Abdulhaq, A., Verma, R., Sharma, K., Kumar, D., Kumar, A., Tapwal, A., Yadav, R., & Mohan, S. (2023). Improvement in the Phytochemical Content and Biological Properties of Stevia rebaudiana (Bertoni) Bertoni Plant Using Endophytic Fungi Fusarium fujikuroi. Plants, 12(5), 1151. https://doi.org/10.3390/plants12051151

